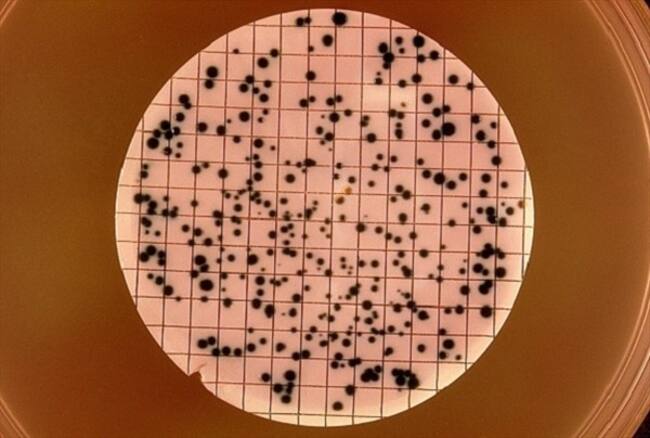
ADN

Paciente presenta el peor caso de súpergonorrea del mundo
Los antibióticos no han tenido ningún efecto sobre el enfermo.

Un paciente británico ha conmocionado a la comunidad científica al presentar el peor caso de súpergonorrea que se haya registrado en la literatura médica mundial.
Según Public Health England, el individuo contrajo la enfermedad de transmisión sexual (ETS) en un viaje al sudeste asiático y hasta ahora se ha mostrado intratable.
Al acudir al hospital para recibir tratamiento, ninguno de los antibióticos recomendados para esta infección –azitromicina y ceftriaxona– tuvo efectos sobre él.
El servicio de salud británico se ha abocado a la tarea de rastrear a las parejas sexuales de este hombre para contener la propagación de la enfermedad. Afortunadamente, su actual pareja dio negativo.
La doctora responsable del caso, Gwenda Hughes, detalla que "esta es la primera vez que un caso muestra una resistencia de tan alto nivel a estos dos medicamentos y a la mayoría de los otros antibióticos comúnmente usados".
Un informe de la Organización Mundial de la Salud (OMS), basado en datos procedentes de 77 países, advirtió en 2017 su preocupación por un aumento de la gonorrea resistente a los antibióticos, que hacía necesario el uso de nuevos fármacos.
La gonorrea es causada por una bacteria del tipo gonococo conocida como Neisseria gonorrhoeae. La infección se puede transmitir por vía oral, anal y vaginal sin protección.

La enfermedad a veces se presenta de manera asintomática en un porcentaje importante de la sociedad, sin embargo, en la mayoría puede incluir una secreción espesa verde o amarilla de los órganos sexuales, dolor al orinar y sangrado.
La infección no tratada puede provocar infertilidad, enfermedad inflamatoria pélvica y puede transmitirse a un niño durante el embarazo.
En Chile, los casos de gonorrea aumentaron más del 200 por ciento en el último año.
Sigue a ADN.cl en Google Discover
Recibe nuestros contenidos directamente en tu feed.
























